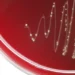

فهرست مطالب
فیزیکدانان دانشگاه کلرادو برای نخستینبار یک کریستال زمان ساختهاند که با چشم انسان قابل مشاهده است.
به گزارش تکناک، پدیده کریستال زمان (Time Crystal) از تازهترین مفاهیم دنیای فیزیک است. این ایده نخستین بار در سال ۲۰۱۲ توسط فرانک ویلچک، فیزیکدان نظری آمریکایی مطرح شد، اما بسیاری از دانشمندان آن را در ابتدا مفهومی خلاف قوانین ترمودینامیک دانستند.
گروهی از فیزیکدانان آمریکایی در سال 2016 برای نخستینبار توانستند وجود آن را در آزمایشگاه مشاهده کنند.

01
از 03تفاوت کریستال زمان با کریستالهای معمولی
کریستالهای رایج مانند الماس، کوارتز و نمک از شبکههای سهبعدی اتمی ساخته شدهاند، که الگوی آنها در فضا به طور منظم تکرار میشود. اما کریستال زمان علاوه بر فضا، در بُعد زمان نیز الگوی تکراری دارد.
ذرات در این نوع کریستال با ریتمی نوسان میکنند که مستقل از شرایط محیطی است و این پدیده به شکلی منحصربهفرد، تقارن زمانی را میشکند.
02
از 03چگونگی ساخت
در پژوهشی جدید، هانگچینگ ژائو و ایوان اسملیوک از دانشگاه کلرادو بولدر موفق شدند کریستالی زمانمحور بسازند، که نه تنها زیر میکروسکوپ، بلکه در شرایط خاص با چشم غیرمسلح نیز دیده میشود.
- آنها برای ساخت این کریستال از کریستالهای مایع بهره بردند، یعنی همان موادی که در نمایشگرهای LCD ساعتها و تلویزیونها استفاده میشوند.
- این کریستال مایع بین دو صفحه شیشهای پوشیده از رنگ حساس به نور قرار گرفت.
- با تاباندن نوع خاصی از نور، مولکولهای رنگ تغییر جهت دادند و به کریستال مایع فشار وارد کردند.
- این فشار، الگوهایی مارپیچی و نوارهای رنگی ایجاد کرد که حتی با تغییر نور و دما، ساعتها پایدار باقی ماندند.
اسملیوک در توصیف این دستاورد گفت: «همهچیز میتواند از هیچ شکل بگیرد؛ فقط کافی است نور بتابانید تا مادهای شگفتانگیز با الگوی منظم در زمان ظاهر شود.»

03
از 03کاربردهای شگفتانگیز کریستال زمان
نتایج این پژوهش نه تنها معیارهای علمی لازم برای تعریف یک کریستال زمان را برآورده میکند، بلکه چشمانداز تازهای از فناوریهای آینده را آشکار میسازد. از جمله کاربردهای احتمالی میتوان به موارد زیر اشاره کرد:
- فناوریهای نوری
- ابزارهای امنیتی
- ساخت بارکدهای دوبعدی
- توسعه فناوریهای مخابراتی
پژوهشگران تأکید کردهاند که این تنها آغاز راه است و بررسی کریستالهای زمان در سیستمها و شرایط گوناگون میتواند معیارهای تازهای برای شناخت این پدیده ارائه دهد.